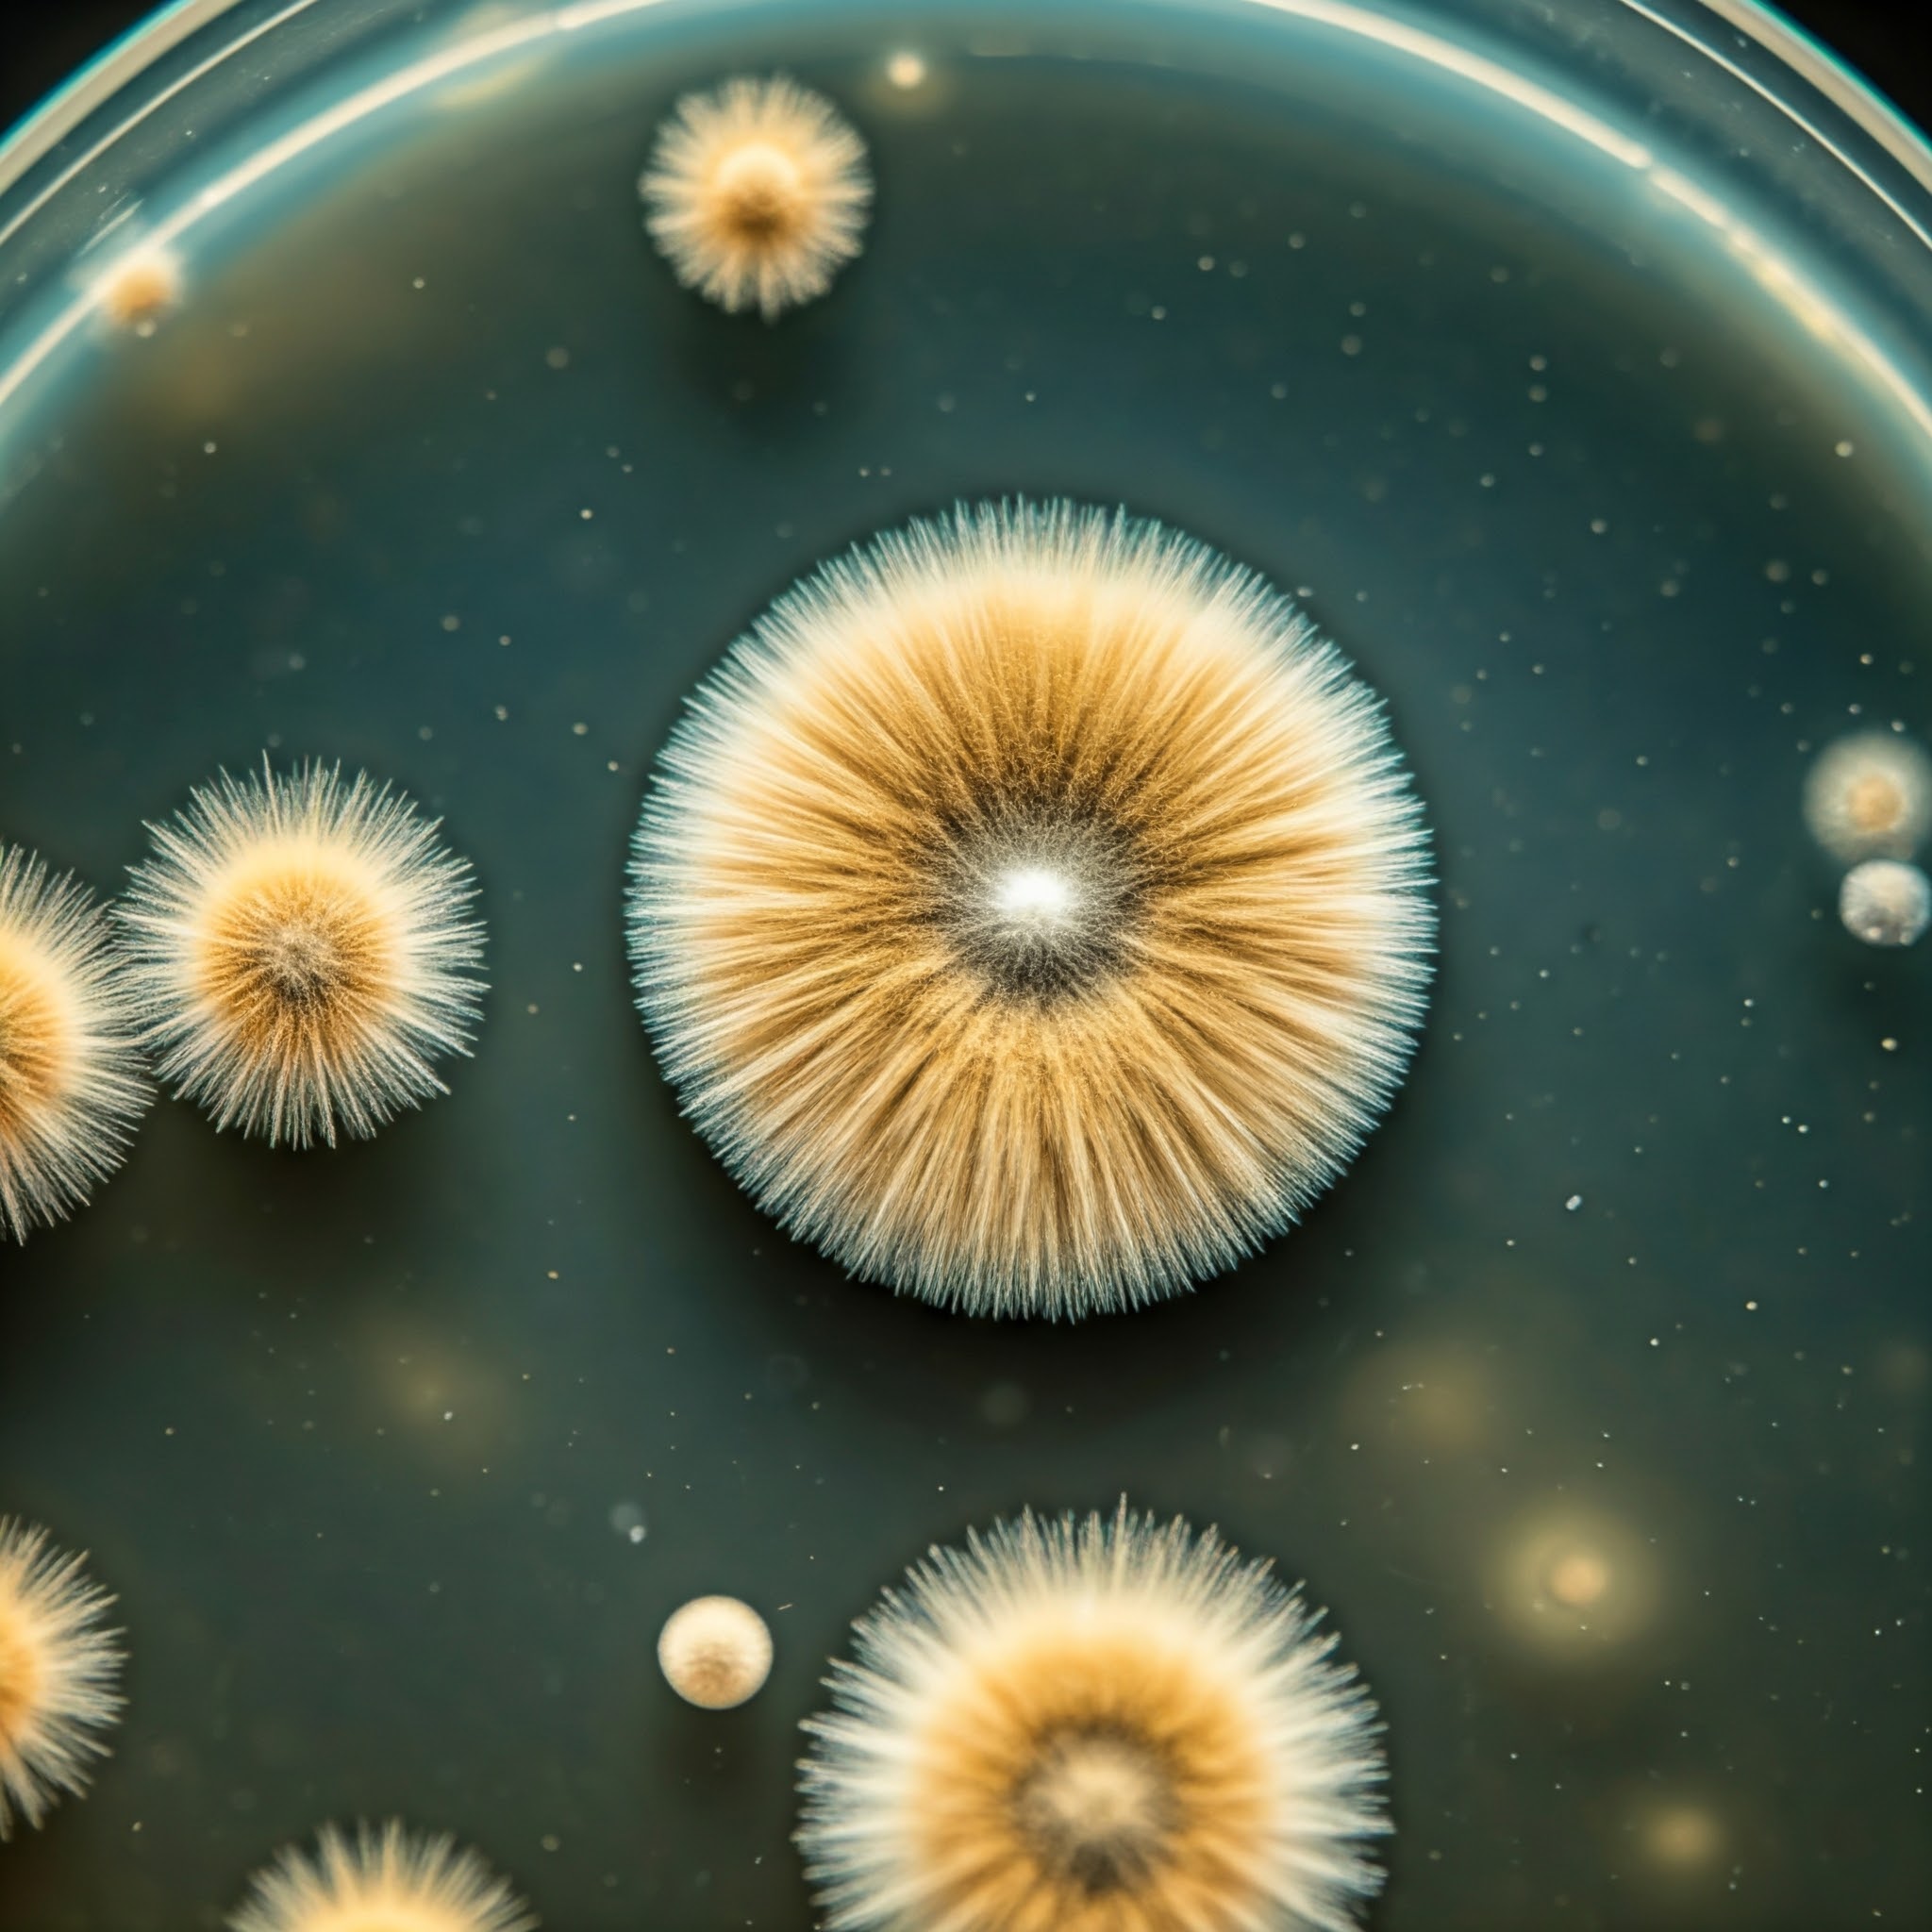

Why handling mould is so important
Both Mould & Mould Mycotoxins* Can Cause Health Problems
(* myco = Greek for fungus, toxin = a poisonous substance).
These toxins include the generally invisible spores in the air that enable mould to spread. Normal cleaning, even with “mould removal” products, can do more harm than good by releasing these into the air and spreading them.

Mould affects different people in different ways
Exposure to mould can cause allergic reactions, and repeated exposure can make these more severe. The problems are worse indoors.
Health symptoms that can be caused by mould
Moulds have the potential to cause health problems.
United States Environmental Protection Agency
“Allergic reactions to mould are common. They can be immediate or delayed. Moulds can also cause asthma attacks in people with asthma who are allergic to mold. In addition, mould exposure can irritate the eyes, skin, nose, throat, and lungs of both mold-allergic and non-allergic people.”
Symptoms to watch out for
Different types of mould affect us in different ways:

Allergenic
Allergenic moulds can produce allergy-like reactions or symptoms in people who breathe in spores or come into contact with them. Allergenic moulds can cause congestion, diarrhea, dizziness, sneezing, a runny nose, itching, and/or dry skin. Allergenic moulds can also trigger asthma-like episodes.
Aspergillus • Alternaria • Cladosporium • Penicillium • Fusarium • Epicoccum
Pathogenic
Pathogenic moulds can produce illnesses, infections, or diseases in people even if they are otherwise healthy. These effects can range from skin and nail infections, to systemic reactions that may even become life-threatening, such as lung, kidney, and liver diseases or infections. .
Aspergillus flavus • Alternaria • Cladosporium • Penicillium • Fusarium • Epicoccum

Toxigenic
Toxigenic moulds are mould species or genus that may produce a toxin, of which there are 20 common ones. These toxins are a metabolic byproduct called mycotoxins. Mycotoxin is derived from the Greek words for fungus + toxin. Toxigenic moulds can cause a toxic response in people and animals.
Fusarium • Penicillium • Aspergillus niger • Stachybotrys chartarum
